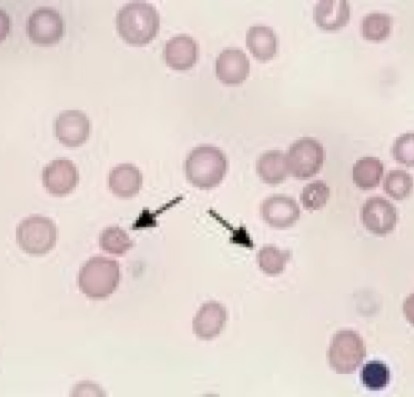

Sign up for FlowVella
Sign up with FacebookAlready have an account? Sign in now
By registering you are agreeing to our
Terms of Service
Loading Flow


Heinz Body
These cells are commonly known to have a small "nose" on top of cell, a rounded projection from RBC membrane, and are a cause of deoxidation of hemoglobin.
Common diseases/conditions are hepatic lipidosis, diabetes mellitus, and hyperthyroidism.